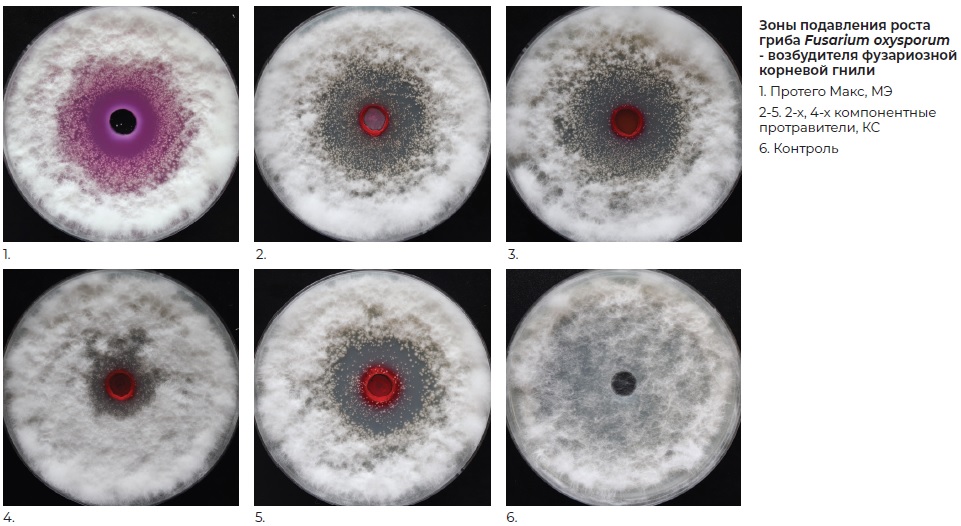
Протего Макс - Фунгицидная активность протравителей семян против возбудителей заболеваний.jpg Протего Макс - Фунгицидная активность протравителей семян против возбудителей заболеваний.jpg

Протего Макс, МЭ
Эко Плюс
микроэмульсия
75 г/л протиоконазола + 25 г/л пираклостробина + 25 г/л тебуконазола
Фунгицидный протравитель семян в инновационной формуляции для защиты зерновых культур и получения высоких урожаев в условиях повышенного риска возникновения заболеваний.
Преимущества:
- Защита «премиум-класса» за счет нового, максимально эффективного сочетания 3-х наиболее активных компонентов и инновационной формуляции
- Наилучшая эффективность в условиях высокой инфекционной нагрузки и длительное защитное действие от семени до флаг-листа
- Усиленное действие против возбудителей фузариозов, септориозов, болезней прикорневой зоны, а также гибеллиноза
- Иммуностимулирующее действие
- Ярко выраженный физиологический эффект: мощные всходы, крепкая корневая система, высокий коэффициент кущения, повышение фотосинтезирующей активности
- Высокая зимостойкость и устойчивость к засухе, а также стойкость растений к перепадам температур
- Получение максимальной урожайности и зерна высокого качества
Действие препарата
Регламент применения
Общая информация
Лабораторные результаты
Полевые результаты
Отзывы о товаре
ОАО "Крошин" РБ, 2022 г
Осенью 2021 г. было посеяно с применением Протего Макс, МЭ 25% озимого ячменя и 15% площади озимой пшеницы. Урожайность озимого ячменя составила 80,4 ц/га при средней 72,3 ц/га, а озимой пшеницы 76,7 ц/га при средней 68,5 ц/га.
Весной 2022 г. 100% ярового пивоваренного ячменя было посеяно с протравителем Протего Макс, МЭ, продуктивность составила 67,4 ц/га при внесении азотного питания не более 60 кг/га. Фунгицидная обработка при этом была проведена однократно в фазу колошения в связи с тем, что в посеве не было распространения ринхоспориоза и сетчатой пятнистости даже в фазу флагового листа. Считаю, что это напрямую связано с длительным защитным действием протравителя Протего Макс.
Весной 2022 г. 100% ярового пивоваренного ячменя было посеяно с протравителем Протего Макс, МЭ, продуктивность составила 67,4 ц/га при внесении азотного питания не более 60 кг/га. Фунгицидная обработка при этом была проведена однократно в фазу колошения в связи с тем, что в посеве не было распространения ринхоспориоза и сетчатой пятнистости даже в фазу флагового листа. Считаю, что это напрямую связано с длительным защитным действием протравителя Протего Макс.